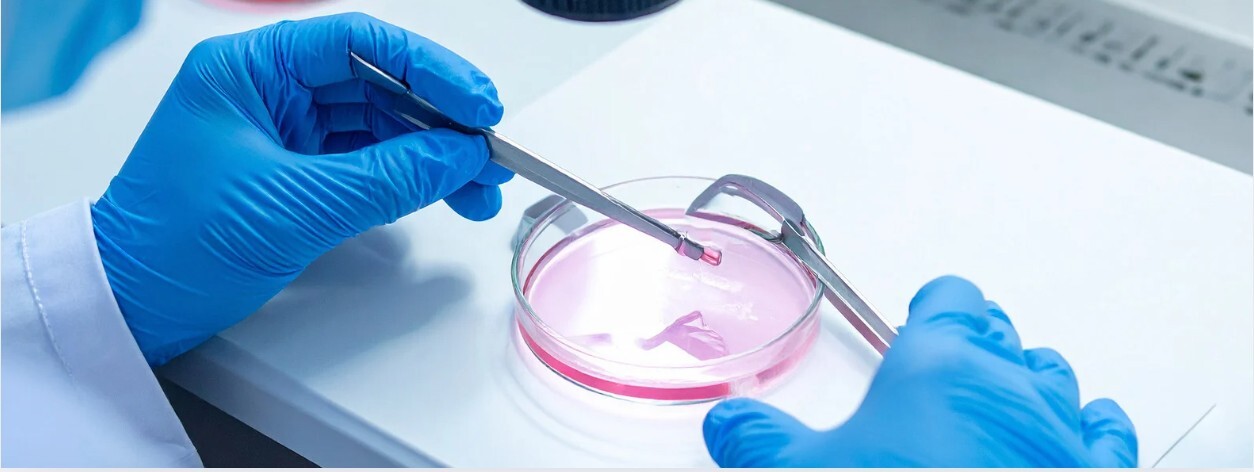
IVF-Acronyms-Explained

.
Decoding Fertility Acronyms: A UK Guide to IVF, IUI, AMH, FSH and More
The world of fertility treatment can often feel like it’s written in a different language, filled with a confusing array of acronyms and medical jargon. At Harley Street Fertility Clinic, we believe that understanding these terms is the first step towards feeling empowered and in control of your fertility journey. This guide breaks down the most common fertility acronyms you’ll encounter in the UK, explaining what they mean, why they matter, and how they relate to your path to parenthood.
The Key Diagnostic Terms: Understanding Your Body
Before discussing treatment, it's vital to understand the terms used in your diagnosis.
AMH (Anti-Müllerian Hormone)
- What it is: A hormone produced by the small follicles in your ovaries.
- What it measures: Your ovarian reserve – essentially, the estimated number of eggs you have remaining. It's a key indicator of your fertility potential.
- What it means: A low AMH level suggests a diminished ovarian reserve, which is often age-related but can occur in younger women too. A high AMH can be a sign of PCOS. It’s important to note that AMH is a measure of quantity, not necessarily quality.
FSH (Follicle-Stimulating Hormone)
- What it is: A hormone produced by the pituitary gland in your brain that stimulates the ovaries to grow a follicle each month.
- What it measures: Ovarian function. A high FSH level (especially on Day 2-5 of your cycle) indicates your pituitary gland is working harder to stimulate your ovaries, which can suggest a declining ovarian reserve.
AFC (Antral Follicle Count)
- What it is: The number of small, resting follicles observed in your ovaries during a transvaginal ultrasound scan at the start of your cycle.
- What it measures: Like AMH, it’s a direct measure of your ovarian reserve. A higher AFC is generally favourable for fertility treatment.
HSG / HyCoSy (Hysterosalpingo-Contrast-Sonography)
- What it is: A specialised ultrasound scan.
- What it checks: Whether your fallopian tubes are open (patent) and that the cavity of your womb is normal. It’s a crucial test to ensure eggs and sperm can meet and that an embryo can travel to the womb.
The Treatment Pathways: Your Options Explained
IUI (Intrauterine Insemination)
- What it is: A procedure where washed and prepared sperm is placed directly into the womb around the time of ovulation.
- How it works: It bypasses the cervix, giving sperm a head start. It’s often recommended for mild male factor infertility, unexplained infertility, or for women using donor sperm.
- Key point: It is less complex and less expensive than IVF, but success rates per cycle are generally lower.
IVF (In Vitro Fertilisation)
- What it is: A process where eggs are collected from the ovaries and fertilised with sperm in a laboratory dish (“in vitro” means “in glass”).
- How it works: The woman undergoes ovarian stimulation with injections to produce multiple eggs. After egg collection, the embryos are grown in an incubator for 3-5 days before one (or sometimes two) are transferred back into the womb.
ICSI (Intracytoplasmic Sperm Injection)
- What it is: A specialised form of IVF.
- How it works: A single sperm is injected directly into an egg. It is used to overcome severe male factor infertility where sperm count, motility, or morphology is poor. It is also used if previous IVF cycles have resulted in failed fertilisation.
The Crucial Embryology Terms
Blastocyst
What it is: An embryo that has developed for 5-6 days after fertilisation.
Why it matters: Transferring an embryo at the blastocyst stage allows for better embryo selection, as not all embryos survive to this point. This can lead to higher success rates per transfer.
ET (Embryo Transfer)
What it is: The procedure where the embryo(s) are placed into the womb using a fine catheter. This is the final step in an IVF cycle.
Why This Knowledge Matters for Your UK Treatment
Understanding these terms allows you to have informed, productive conversations with your fertility specialist. It enables you to:
- Ask the right questions about your test results and treatment plan.
- Understand the reasoning behind your personalised protocol.
- Feel like an active participant in your care, rather than a passive patient.
At Harley Street Fertility Clinic, we never want you to feel lost in a sea of acronyms. Our team is dedicated to explaining every step of your journey in clear, accessible language.
If you have any questions about these terms or want to discuss what they mean for your personal fertility journey, don’t hesitate to contact our supportive team at Harley Street Fertility Clinic for a consultation.
.jpg?upsize=true&upscale=true&width=400&height=200&name=Untitled%20design%20(1).jpg)
